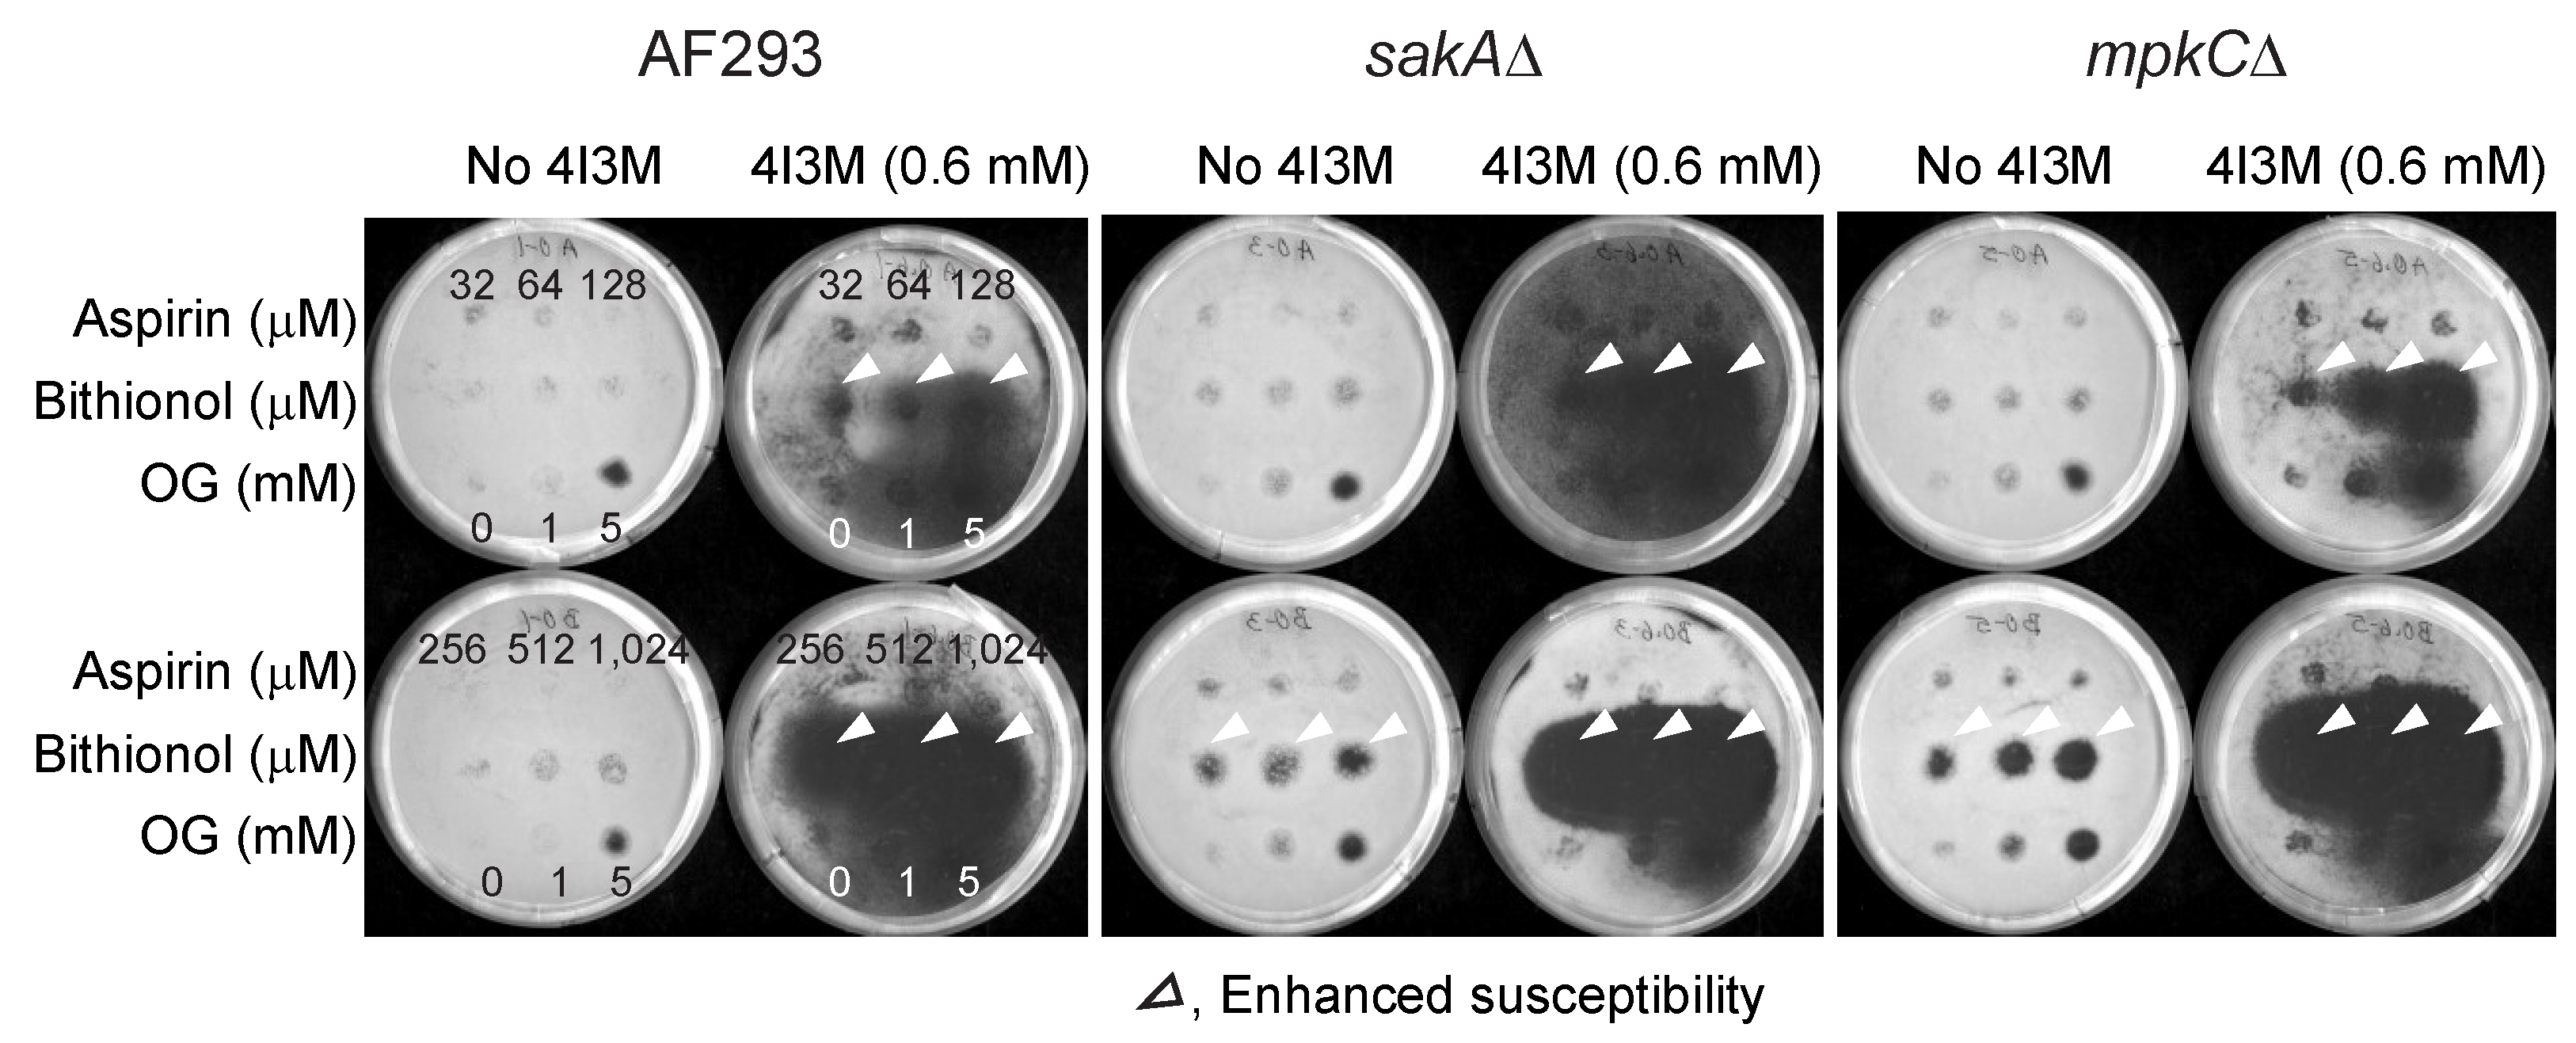
Mps 02 00031 g003 Mps 02 00031 g003

High Efficiency Drug Repurposing Design for New Antifungal Agents
Abstract
1. Introduction
2. Materials and Methods
2.1. Literature Search: PubMed Database
2.2. Chemicals
2.3. Antifungal Bioassay
2.4. Overcoming Fludioxonil Tolerance by Bithionol
2.5. Statistical Analysis
3. Results and Discussion
3.1. Aspirin and Bithionol
3.2. Chemosensitization to Enhance the Efficacy of Repurposed Drugs
3.2.1. Thymol as a Chemosensitizer to Bithionol or Aspirin
3.2.2. 4-Isopropyl-3-Methylphenol as a Chemosensitizer to Bithionol or Aspirin
3.2.3. 3,5-Dimethoxybenzaldehyde as a Chemosensitizer to Bithionol or Aspirin
3.3. Scheme of High-Efficiency Drug Repurposing Design
3.4. Overcoming Fludioxonil Tolerance of Aspergillus Fumigatus MAPK Mutants
4. Conclusions
Supplementary Materials
Author Contributions
Acknowledgments
Conflicts of Interest
References
- Nami, S.; Aghebati-Maleki, A.; Morovati, H.; Aghebati-Maleki, L. Current antifungal drugs and immunotherapeutic approaches as promising strategies to treatment of fungal diseases. Biomed. Pharmacother. 2019, 110, 857–868. [Google Scholar] [CrossRef] [PubMed]
- Nicola, A.M.; Albuquerque, P.; Paes, H.C.; Fernandes, L.; Costa, F.F.; Kioshima, E.S.; Abadio, A.K.R.; Bocca, A.L.; Felipe, M.S. Antifungal drugs: New insights in research & development. Pharmacol. Ther. 2018. [Google Scholar] [CrossRef]
- Beardsley, J.; Halliday, C.L.; Chen, S.C.-A.; Sorrell, T.C. Responding to the emergence of antifungal drug resistance: Perspectives from the bench and the bedside. Future Microbiol. 2018, 13, 1175–1191. [Google Scholar] [CrossRef] [PubMed]
- Meir, Z.; Osherov, N. Vitamin Biosynthesis as an Antifungal Target. J. Fungi 2018, 4, 72. [Google Scholar] [CrossRef]
- Prasad, R.; Shah, A.H.; Rawal, M.K. Antifungals: Mechanism of Action and Drug Resistance. Adv. Exp. Med. Biol. 2016, 892, 327–349. [Google Scholar] [CrossRef] [PubMed]
- Prasad, R.; Singh, A. Lipids of Candida albicans and their role in multidrug resistance. Curr. Genet. 2013, 59, 243–250. [Google Scholar] [CrossRef]
- Wiederhold, N.P. Antifungal resistance: Current trends and future strategies to combat. Infect Drug Resist. 2017, 10, 249–259. [Google Scholar] [CrossRef] [PubMed]
- McCarthy, M.W.; Kontoyiannis, D.P.; Cornely, O.A.; Perfect, J.R.; Walsh, T.J. Novel agents and drug targets to meet the challenges of resistant fungi. J. Infect. Dis. 2017, 216, S474–S483. [Google Scholar] [CrossRef]
- Maschmeyer, G.; Haas, A.; Cornely, O.A. Invasive aspergillosis: Epidemiology, diagnosis and management in immunocompromised patients. Drugs 2007, 67, 1567–1601. [Google Scholar] [CrossRef]
- Rivero-Menendez, O.; Alastruey-Izquierdo, A.; Mellado, E.; Cuenca-Estrella, M. Triazole resistance in Aspergillus spp.: A worldwide problem? J. Fungi 2016, 2, 21. [Google Scholar] [CrossRef]
- Bowyer, P.; Denning, D.W. Environmental fungicides and triazole resistance in Aspergillus. Pest Manag. Sci. 2014, 70, 173–178. [Google Scholar] [CrossRef] [PubMed]
- Chowdhary, A.; Kathuria, S.; Xu, J.; Sharma, C.; Sundar, G.; Singh, P.K.; Gaur, S.N.; Hagen, F.; Klaassen, C.H.; Meis, J.F. Clonal expansion and emergence of environmental multiple-triazole-resistant Aspergillus fumigatus strains carrying the TR(3)(4)/L98H mutations in the cyp51A gene in India. PLoS ONE 2012, 7, e52871. [Google Scholar] [CrossRef]
- Benedict, K.; Chiller, T.M.; Mody, R.K. Invasive fungal infections acquired from contaminated food or nutritional supplements: A review of the literature. Foodborne Pathog. Dis. 2016, 13, 343–349. [Google Scholar] [CrossRef] [PubMed]
- Stylianou, M.; Kulesskiy, E.; Lopes, J.P.; Granlund, M.; Wennerberg, K.; Urban, C.F. Antifungal application of nonantifungal drugs. Antimicrob. Agents Chemother. 2014, 58, 1055–1062. [Google Scholar] [CrossRef] [PubMed]
- Campbell, B.C.; Chan, K.L.; Kim, J.H. Chemosensitization as a means to augment commercial antifungal agents. Front. Microbiol. 2012, 3, 79. [Google Scholar] [CrossRef]
- National Center for Biotechnology Information. PubMed. Available online: https://www.ncbi.nlm.nih.gov/pubmed (accessed on 31 May 2018).
- Kirkman, T.W. Statistics to Use. Available online: http://www.physics.csbsju.edu/stats/ (accessed on 4 February 2019).
- Kleinboelting, S.; Ramos-Espiritu, L.; Buck, H.; Colis, L.; van den Heuvel, J.; Glickman, J.F.; Levin, L.R.; Buck, J.; Steegborn, C. Bithionol potently inhibits human soluble adenylyl cyclase through binding to the allosteric activator site. J. Biol. Chem. 2016, 291, 9776–9784. [Google Scholar] [CrossRef]
- National Center for Biotechnology Information. PubChem Compound Database; CID=445643. Available online: https://pubchem.ncbi.nlm.nih.gov/compound/445643 (accessed on 30 January 2019).
- National Center for Biotechnology Information. PubChem Compound Database; CID=5790. Available online: https://pubchem.ncbi.nlm.nih.gov/compound/5790 (accessed on 30 January 2019).
- National Center for Biotechnology Information. PubChem Compound Database; CID=16667669. Available online: https://pubchem.ncbi.nlm.nih.gov/compound/16667669 (accessed on 30 January 2019).
- National Center for Biotechnology Information. PubChem Compound Database; CID=68873. Available online: https://pubchem.ncbi.nlm.nih.gov/compound/68873 (accessed on 30 January 2019).
- National Center for Biotechnology Information. PubChem Compound Database; CID=4746. Available online: https://pubchem.ncbi.nlm.nih.gov/compound/4746 (accessed on 30 January 2019).
- National Center for Biotechnology Information. PubChem Compound Database; CID=3005573. Available online: https://pubchem.ncbi.nlm.nih.gov/compound/3005573 (accessed on 30 January 2019).
- National Center for Biotechnology Information. PubChem Compound Database; CID=2244. Available online: https://pubchem.ncbi.nlm.nih.gov/compound/2244 (accessed on 30 January 2019).
- National Center for Biotechnology Information. PubChem Compound Database; CID=3672. Available online: https://pubchem.ncbi.nlm.nih.gov/compound/3672 (accessed on 30 January 2019).
- National Center for Biotechnology Information. PubChem Compound Database; CID=10982. Available online: https://pubchem.ncbi.nlm.nih.gov/compound/10982#section=Biological-Test-Results (accessed on 30 January 2019).
- National Center for Biotechnology Information. PubChem Compound Database; CID=2157. Available online: https://pubchem.ncbi.nlm.nih.gov/compound/2157 (accessed on 30 January 2019).
- National Center for Biotechnology Information. PubChem Compound Database; CID=5452. Available online: https://pubchem.ncbi.nlm.nih.gov/compound/5452 (accessed on 30 January 2019).
- National Center for Biotechnology Information. PubChem Compound Database; CID=6917864. Available online: https://pubchem.ncbi.nlm.nih.gov/compound/6917864 (accessed on 30 January 2019).
- National Center for Biotechnology Information. PubChem Compound Database; CID=3598. Available online: https://pubchem.ncbi.nlm.nih.gov/compound/3598 (accessed on 30 January 2019).
- National Center for Biotechnology Information. PubChem Compound Database; CID=54680693. Available online: https://pubchem.ncbi.nlm.nih.gov/compound/54680693#section=Pharmacology-and-Biochemistry (accessed on 30 January 2019).
- National Center for Biotechnology Information. PubChem Compound Database; CID=237. Available online: https://pubchem.ncbi.nlm.nih.gov/compound/237 (accessed on 30 January 2019).
- National Center for Biotechnology Information. PubChem Compound Database; CID=2907. Available online: https://pubchem.ncbi.nlm.nih.gov/compound/2907 (accessed on 30 January 2019).
- National Center for Biotechnology Information. PubChem Compound Database; CID=15547703. Available online: https://pubchem.ncbi.nlm.nih.gov/compound/15547703 (accessed on 30 January 2019).
- National Center for Biotechnology Information. PubChem Compound Database; CID=2719. Available online: https://pubchem.ncbi.nlm.nih.gov/compound/2719 (accessed on 30 January 2019).
- National Center for Biotechnology Information. PubChem Compound Database; CID=5493444. Available online: https://pubchem.ncbi.nlm.nih.gov/compound/5493444 (accessed on 30 January 2019).
- National Center for Biotechnology Information. PubChem Compound Database; CID=60823. Available online: https://pubchem.ncbi.nlm.nih.gov/compound/60823 (accessed on 30 January 2019).
- Sun, W.; Park, Y.D.; Sugui, J.A.; Fothergill, A.; Southall, N.; Shinn, P.; McKew, J.C.; Kwon-Chung, K.J.; Zheng, W.; Williamson, P.R. Rapid identification of antifungal compounds against Exserohilum rostratum using high throughput drug repurposing screens. PLoS ONE 2013, 8, e70506. [Google Scholar] [CrossRef]
- Thangamani, S.; Maland, M.; Mohammad, H.; Pascuzzi, P.E.; Avramova, L.; Koehler, C.M.; Hazbun, T.R.; Seleem, M.N. Repurposing approach identifies auranofin with broad spectrum antifungal activity that targets Mia40-Erv1 pathway. Front. Cell. Infect. Microbiol. 2017, 7, 4. [Google Scholar] [CrossRef]
- Wiederhold, N.P.; Patterson, T.F.; Srinivasan, A.; Chaturvedi, A.K.; Fothergill, A.W.; Wormley, F.L.; Ramasubramanian, A.K.; Lopez-Ribot, J.L. Repurposing auranofin as an antifungal: In vitro activity against a variety of medically important fungi. Virulence 2017, 8, 138–142. [Google Scholar] [CrossRef]
- Delattin, N.; De Brucker, K.; Vandamme, K.; Meert, E.; Marchand, A.; Chaltin, P.; Cammue, B.P.; Thevissen, K. Repurposing as a means to increase the activity of amphotericin B and caspofungin against Candida albicans biofilms. J. Antimicrob. Chemother. 2014, 69, 1035–1044. [Google Scholar] [CrossRef]
- Ogundeji, A.O.; Pohl, C.H.; Sebolai, O.M. Repurposing of aspirin and ibuprofen as candidate anti-Cryptococcus drugs. Antimicrob. Agents Chemother. 2016, 60, 4799–4808. [Google Scholar] [CrossRef] [PubMed]
- Sebastian-Perez, V.; Manoli, M.T.; Perez, D.I.; Gil, C.; Mellado, E.; Martinez, A.; Espeso, E.A.; Campillo, N.E. New applications for known drugs: Human glycogen synthase kinase 3 inhibitors as modulators of Aspergillus fumigatus growth. Eur. J. Med. Chem. 2016, 116, 281–289. [Google Scholar] [CrossRef]
- Kim, K.; Zilbermintz, L.; Martchenko, M. Repurposing FDA approved drugs against the human fungal pathogen, Candida albicans. Ann. Clin. Microbiol. Antimicrob. 2015, 14, 32. [Google Scholar] [CrossRef] [PubMed]
- Butts, A.; DiDone, L.; Koselny, K.; Baxter, B.K.; Chabrier-Rosello, Y.; Wellington, M.; Krysan, D.J. A repurposing approach identifies off-patent drugs with fungicidal cryptococcal activity, a common structural chemotype, and pharmacological properties relevant to the treatment of cryptococcosis. Eukaryot. Cell 2013, 12, 278–287. [Google Scholar] [CrossRef] [PubMed]
- De Cremer, K.; Lanckacker, E.; Cools, T.L.; Bax, M.; De Brucker, K.; Cos, P.; Cammue, B.P.; Thevissen, K. Artemisinins, new miconazole potentiators resulting in increased activity against Candida albicans biofilms. Antimicrob. Agents Chemother. 2015, 59, 421–426. [Google Scholar] [CrossRef]
- Kulkarny, V.V.; Chavez-Dozal, A.; Rane, H.S.; Jahng, M.; Bernardo, S.M.; Parra, K.J.; Lee, S.A. Quinacrine inhibits Candida albicans growth and filamentation at neutral pH. Antimicrob. Agents Chemother. 2014, 58, 7501–7509. [Google Scholar] [CrossRef] [PubMed]
- Routh, M.M.; Chauhan, N.M.; Karuppayil, S.M. Cancer drugs inhibit morphogenesis in the human fungal pathogen, Candida albicans. Braz. J. Microbiol. 2013, 44, 855–859. [Google Scholar] [CrossRef]
- Shinde, R.B.; Rajput, S.B.; Raut, J.S.; Karuppayil, S.M. An in vitro repositioning study reveals antifungal potential of chloroquine to inhibit growth and morphogenesis in Candida albicans. J. Gen. Appl. Microbiol. 2013, 59, 167–170. [Google Scholar] [CrossRef]
- Kathwate, G.H.; Karuppayil, S.M. Antifungal properties of the anti-hypertensive drug: Aliskiren. Arch. Oral. Biol. 2013, 58, 1109–1115. [Google Scholar] [CrossRef]
- Ribeiro, N.Q.; Costa, M.C.; Magalhaes, T.F.F.; Carneiro, H.C.S.; Oliveira, L.V.; Fontes, A.C.L.; Santos, J.R.A.; Ferreira, G.F.; Araujo, G.R.S.; Alves, V.; et al. Atorvastatin as a promising anticryptococcal agent. Int. J. Antimicrob. Agents 2017, 49, 695–702. [Google Scholar] [CrossRef]
- Ma, Y.; Liang, S.; Zhang, Y.; Yang, D.; Wang, R. Development of anti-fungal pesticides from protein kinase inhibitor-based anticancer agents. Eur. J. Med. Chem. 2018, 148, 349–358. [Google Scholar] [CrossRef] [PubMed]
- Ayyagari, V.N.; Diaz-Sylvester, P.L.; Hsieh, T.J.; Brard, L. Evaluation of the cytotoxicity of the bithionol-paclitaxel combination in a panel of human ovarian cancer cell lines. PLoS ONE 2017, 12, e0185111. [Google Scholar] [CrossRef] [PubMed]
- Balzan, R.; Sapienza, K.; Galea, D.R.; Vassallo, N.; Frey, H.; Bannister, W.H. Aspirin commits yeast cells to apoptosis depending on carbon source. Microbiology 2004, 150, 109–115. [Google Scholar] [CrossRef]
- Reyes, G.; Romans, A.; Nguyen, C.K.; May, G.S. Novel mitogen-activated protein kinase MpkC of Aspergillus fumigatus is required for utilization of polyalcohol sugars. Eukaryot. Cell 2006, 5, 1934–1940. [Google Scholar] [CrossRef] [PubMed]
- Xue, T.; Nguyen, C.K.; Romans, A.; May, G.S. A mitogen-activated protein kinase that senses nitrogen regulates conidial germination and growth in Aspergillus fumigatus. Eukaryot. Cell 2004, 3, 557–560. [Google Scholar] [CrossRef] [PubMed]
- Kim, J.H.; Chan, K.L.; Faria, N.C.; Martins Mde, L.; Campbell, B.C. Targeting the oxidative stress response system of fungi with redox-potent chemosensitizing agents. Front. Microbiol. 2012, 3, 88. [Google Scholar] [CrossRef] [PubMed]
- Kim, J.H.; Chan, K.L.; Mahoney, N.; Campbell, B.C. Antifungal activity of redox-active benzaldehydes that target cellular antioxidation. Ann. Clin. Microbiol. Antimicrob. 2011, 10, 23. [Google Scholar] [CrossRef] [PubMed]
- Bacq, Y.; Besnier, J.M.; Duong, T.H.; Pavie, G.; Metman, E.H.; Choutet, P. Successful treatment of acute fascioliasis with bithionol. Hepatology 1991, 14, 1066–1069. [Google Scholar] [CrossRef] [PubMed]
- Ayyagari, V.N.; Brard, L. Bithionol inhibits ovarian cancer cell growth in vitro - studies on mechanism(s) of action. BMC Cancer 2014, 14, 61. [Google Scholar] [CrossRef]
- Llana-Ruiz-Cabello, M.; Gutierrez-Praena, D.; Puerto, M.; Pichardo, S.; Jos, A.; Camean, A.M. In vitro pro-oxidant/antioxidant role of carvacrol, thymol and their mixture in the intestinal Caco-2 cell line. Toxicol. In Vitro 2015, 29, 647–656. [Google Scholar] [CrossRef]
- Saccharomyces Genome Database. Available online: www.yeastgenome.org (accessed on 4 February 2019).
- Lee, A.Y.; St.Onge, R.P.; Proctor, M.J.; Wallace, I.M.; Nile, A.H.; Spagnuolo, P.A.; Jitkova, Y.; Gronda, M.; Wu, Y.; Kim, M.K.; et al. Mapping the cellular response to small molecules using chemogenomic fitness signatures. Science 2014, 344, 208–211. [Google Scholar] [CrossRef] [PubMed]
- Norris, M.; Lovell, S.; Delneri, D. Characterization and prediction of haploinsufficiency using systems-level gene properties in yeast. G3 (Bethesda) 2013, 3, 1965–1977. [Google Scholar] [CrossRef] [PubMed]
- Parsons, A.B.; Brost, R.L.; Ding, H.; Li, Z.; Zhang, C.; Sheikh, B.; Brown, G.W.; Kane, P.M.; Hughes, T.R.; Boone, C. Integration of chemical-genetic and genetic interaction data links bioactive compounds to cellular target pathways. Nat. Biotechnol. 2004, 22, 62–69. [Google Scholar] [CrossRef] [PubMed]
- Kim, J.H.; Campbell, B.C.; Yu, J.; Mahoney, N.; Chan, K.L.; Molyneux, R.J.; Bhatnagar, D.; Cleveland, T.E. Examination of fungal stress response genes using Saccharomyces cerevisiae as a model system: Targeting genes affecting aflatoxin biosynthesis by Aspergillus flavus Link. Appl. Microbiol. Biotechnol. 2005, 67, 807–815. [Google Scholar] [CrossRef] [PubMed]
- Kim, J.H.; Hart-Cooper, W.; Chan, K.L.; Cheng, L.W.; Orts, W.J.; Johnson, K. Antifungal efficacy of octylgallate and 4-isopropyl-3-methylphenol for control of Aspergillus. Microbiol. Discov. 2016, 4, 2. [Google Scholar] [CrossRef][Green Version]
- Kim, J.H.; Mahoney, N.; Chan, K.L.; Campbell, B.C.; Haff, R.P.; Stanker, L.H. Use of benzo analogs to enhance antimycotic activity of kresoxim methyl for control of aflatoxigenic fungal pathogens. Front. Microbiol. 2014, 5, 87. [Google Scholar] [CrossRef]
- Kim, J.H.; Chan, K.L.; Mahoney, N. Augmenting the activity of monoterpenoid phenols against fungal pathogens using 2-hydroxy-4-methoxybenzaldehyde that target cell wall integrity. Int. J. Mol. Sci. 2015, 16, 26850–26870. [Google Scholar] [CrossRef]
- Clinical and Laboratory Standards Institute (CLSI). Reference Method for Broth Dilution Antifungal Susceptibility Testing of Filamentous Fungi: Approved Standard–Second Edition; CLSI document M38-A2; Clinical and Laboratory Standards Institute: Wayne, PA, USA, 2008; Volume 28. [Google Scholar]
- Arendrup, M.C.; Cuenca-Estrella, M.; Lass-Flörl, C.; Hope, W. EUCAST technical note on the EUCAST definitive document EDef 7.2: Method for the determination of broth dilution minimum inhibitory concentrations of antifungal agents for yeasts EDef 7.2 (EUCAST-AFST). Clin. Microbiol. Infect. 2012, 18, E246–E247. [Google Scholar] [CrossRef]
- Niimi, K.; Harding, D.R.; Parshot, R.; King, A.; Lun, D.J.; Decottignies, A.; Niimi, M.; Lin, S.; Cannon, R.D.; Goffeau, A.; et al. Chemosensitization of fluconazole resistance in Saccharomyces cerevisiae and pathogenic fungi by a D-octapeptide derivative. Antimicrob. Agents Chemother. 2004, 48, 1256–1271. [Google Scholar] [CrossRef]
- Batova, M.; Klobucnikova, V.; Oblasova, Z.; Gregan, J.; Zahradnik, P.; Hapala, I.; Subik, J.; Schuller, C. Chemogenomic and transcriptome analysis identifies mode of action of the chemosensitizing agent CTBT (7-chlorotetrazolo[5,1-c]benzo[1,2,4]triazine). BMC Genom. 2010, 11, 153. [Google Scholar] [CrossRef]
- Shirazi, F.; Kontoyiannis, D.P. Mitochondrial respiratory pathways inhibition in Rhizopus oryzae potentiates activity of posaconazole and itraconazole via apoptosis. PLoS ONE 2013, 8, e63393. [Google Scholar] [CrossRef] [PubMed]
- Kim, J.H.; Mahoney, N.; Chan, K.L.; Molyneux, R.J.; May, G.S.; Campbell, B.C. Chemosensitization of fungal pathogens to antimicrobial agents using benzo analogs. FEMS Microbiol. Lett. 2008, 281, 64–72. [Google Scholar] [CrossRef] [PubMed]
- Kojima, K.; Takano, Y.; Yoshimi, A.; Tanaka, C.; Kikuchi, T.; Okuno, T. Fungicide activity through activation of a fungal signalling pathway. Mol. Microbiol. 2004, 53, 1785–1796. [Google Scholar] [CrossRef] [PubMed]
- Levin, D.E. Cell wall integrity signaling in Saccharomyces cerevisiae. Microbiol. Mol. Biol. Rev. 2005, 69, 262–291. [Google Scholar] [CrossRef]
- Schwartz, M.A.; Madhani, H.D. Principles of MAP kinase signaling specificity in Saccharomyces cerevisiae. Annu. Rev. Genet. 2004, 38, 725–748. [Google Scholar] [CrossRef]
- DrugCentral. Available online: http://drugcentral.org (accessed on 7 April 2019).
- Aggregate Analysis of ClinicalTrials.gov (AACT). Available online: https://aact.ctti-clinicaltrials.org/ (accessed on 7 April 2019).

| Compounds | Functions | Repositioning Methods | Target Fungi | References |
|---|---|---|---|---|
| Bithionol | Anti-parasitic drug | High-throughput ATP content assays | Exserohilum rostratum | [39] |
| Tacrolimus | Immunosuppressive agent | The same as above | E. rostratum | [39] |
| Floxuridine | Antimetabolite | The same as above | E. rostratum | [39] |
| Auranofin | Rheumatoid arthritis drug | Clinical & Laboratory Standard Insitute (CLSI) M27-A3 protocol | Candida and Cryptococcus strains | [40] |
| Auranofin | Rheumatoid arthritis drug | CLSI M27-A3 (for yeast) & M38-A2 (for filamentous fungi) protocols | Aspergillus fumigatus, Scedosporium apiospermum, Lomentospora prolificans, Candida albicans, Candida krusei, Cryptococcus neoformans | [41] |
| Drospirenone | Synthetic hormone (birth control pills) w/ethinylestradiol | Enhancement of amphotericin B/caspofungin activity against Candida albicans biofilms (96-well plate assay) | C. albicans, Candida glabrata | [42] |
| Perhexiline | Anti-anginal agent | The same as above | The same as above | [42] |
| Toremifine | Selective oestrogen receptor modulator (Oestrogen receptor-positive breast cancer treatment) | The same as above | The same as above | [42] |
| Aspirin (Acetyl salicylic acid) | Anti-pain, fever, or inflammation drug | European Committee on Antimicrobial Susceptibility Testing (EUCAST) protocol | C. neoformans, Cryptococcus gatti | [43] |
| Ibuprofen | Nonsteroidal anti-inflammatory drug | The same as above | The same as above | [43] |
| Human glycogen synthase kinase 3 (GSK-3) inhibitors | Neurological disorder drug | 24-well plate assay | A. fumigatus | [44] |
| Octodrine from Johns Hopkins Clinical Compound Library version 1.0. | Decongestant drug | CLSI M44-A2 protocol | C. albicans | [45] |
| Amiodarone from Prestwick library (Off-patent, biologically active molecules) | Antiarrhythmic drug | High-throughput adenylate kinase assay | C. neoformans | [46] |
| Thioridazine | Antipsychotic drug | The same as above | C. neoformans | [46] |
| Artesunate from Pharmakon 1600 repositioning library | Antimalarial drug | Miconazole synergy test (Anti-biofilm testing) | C. albicans | [47] |
| Hexachlorophene | Anti-infective (topical) drug | The same as above | C. albicans | [47] |
| Pyrvinium pamoate | Antihelmintic drug | The same as above | C. albicans | [47] |
| Quinacrine | Anti-protozoan drug | 96-well plate anti-biofilm testing | C. albicans | [48] |
| Cyclo-Phosphamide (plus 28 drugs) | Anti-cancer drug | 96-well anti-filamentation assay | C. albicans | [49] |
| Tosedostat from the Enzo & the Institute for Molecular Medicine Finland oncology collection libraries | Anti-cancer (Aminopeptidase inhibitor) drug | EUCAST protocol. | C. albicans, C. glabrata | [14] |
| Chloroquine | Anti-malarial drug | Microtiter well plate yeast-to-hyphae transition assay | C. albicans | [50] |
| Aliskiren | Anti-hypertensive drug | CLSI M27-A2 protocol | C. albicans | [51] |
| Atorvastatin | Anti-hypercholestero-laemia drug | CLSI M27-A3 protocol | C. gatti | [52] |
| P21-activated protein kinase inhibitor | Anti-thyroid cancer drug | Agar plate bioassay | Fusarium oxysporum, Fusarium graminearium, Phytopthora sp., Myrothecium roridum, Helminthosporium maydis. | [53] |
© 2019 by the authors. Licensee MDPI, Basel, Switzerland. This article is an open access article distributed under the terms and conditions of the Creative Commons Attribution (CC BY) license (http://creativecommons.org/licenses/by/4.0/).
Share and Cite
Kim, J.H.; Chan, K.L.; Cheng, L.W.; Tell, L.A.; Byrne, B.A.; Clothier, K.; Land, K.M. High Efficiency Drug Repurposing Design for New Antifungal Agents. Methods Protoc. 2019, 2, 31. https://doi.org/10.3390/mps2020031
Kim JH, Chan KL, Cheng LW, Tell LA, Byrne BA, Clothier K, Land KM. High Efficiency Drug Repurposing Design for New Antifungal Agents. Methods and Protocols. 2019; 2(2):31. https://doi.org/10.3390/mps2020031
Chicago/Turabian StyleKim, Jong H., Kathleen L. Chan, Luisa W. Cheng, Lisa A. Tell, Barbara A. Byrne, Kristin Clothier, and Kirkwood M. Land. 2019. "High Efficiency Drug Repurposing Design for New Antifungal Agents" Methods and Protocols 2, no. 2: 31. https://doi.org/10.3390/mps2020031
APA StyleKim, J. H., Chan, K. L., Cheng, L. W., Tell, L. A., Byrne, B. A., Clothier, K., & Land, K. M. (2019). High Efficiency Drug Repurposing Design for New Antifungal Agents. Methods and Protocols, 2(2), 31. https://doi.org/10.3390/mps2020031








